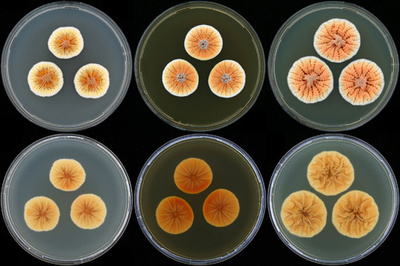
オレンジ色のカビ菌、オランダ皇太子にちなんで名付け

環境・科学
-

20世紀後半、過去1400年で最も温暖
-

初期宇宙の「星大量生産工場」銀河を発見
-

壮観!ブダペストで環境に優しい「自転車デモ」
-

ハッブル宇宙望遠鏡が捉えた馬頭星雲、NASAが公開
-

北極点の氷上に巨大な「目」、環境問題のアートプロジェクト
-

ゼブラフィッシュの全ゲノム配列解読
-

地球に最もよく似た2惑星を発見、NASA
-

シーラカンスのゲノム解読、ほとんど進化していなかった
-

フランスの田園に廃タイヤの山
-

インドネシアのフローレス原人、進化の過程で小型化か
-

オレンジ色のカビ菌、オランダ皇太子にちなんで名付け
-

子の泣き声判別能力に「男女差なし」、仏研究が定説否定
-

「持続可能な魚」ラベルに批判、研究
-

ビールの味だけで報酬感覚、アルコール作用なくても 米研究
-

「北極圏を石油掘削から守って」、グリーンピースが海底にカプセル
-

香港の大気汚染レベルが最高に、今年3度目
-

「バイオ腎臓」、ラットへの移植に成功 米研究
-

南極の夏の氷、10倍の速度で融解 研究